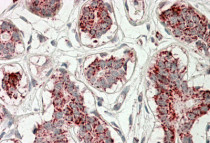

ARG65168
anti-ACO2 / Aconitase 2 antibody
anti-ACO2 / Aconitase 2 antibody for IHC-Formalin-fixed paraffin-embedded sections,Western blot and Human,Mouse,Rat,Pig
Controls and Markers antibody; Metabolism antibody; Signaling Transduction antibody
Overview
| Product Description | Goat Polyclonal antibody recognizes ACO2 / Aconitase 2 |
|---|---|
| Tested Reactivity | Hu, Ms, Rat, Pig |
| Predict Reactivity | Cow, Dog |
| Tested Application | IHC-P, WB |
| Host | Goat |
| Clonality | Polyclonal |
| Isotype | IgG |
| Target Name | ACO2 / Aconitase 2 |
| Antigen Species | Human |
| Immunogen | C-QDTYQHPPKDSSGQH |
| Conjugation | Un-conjugated |
| Alternate Names | Aconitase; ACONM; EC 4.2.1.3; ICRD; Aconitate hydratase, mitochondrial; Citrate hydro-lyase; OCA8; HEL-S-284 |
Application Instructions
| Application Suggestion |
|
||||||
|---|---|---|---|---|---|---|---|
| Application Note | IHC-P: Antigen Retrieval: Steamed with Citrate buffer (pH 6.0). WB: Recommend incubate at RT for 1h. * The dilutions indicate recommended starting dilutions and the optimal dilutions or concentrations should be determined by the scientist. |
Properties
| Form | Liquid |
|---|---|
| Purification | Purified from goat serum by antigen affinity chromatography. |
| Buffer | Tris saline (pH 7.3), 0.02% Sodium azide and 0.5% BSA. |
| Preservative | 0.02% Sodium azide |
| Stabilizer | 0.5% BSA |
| Concentration | 0.5 mg/ml |
| Storage Instruction | For continuous use, store undiluted antibody at 2-8°C for up to a week. For long-term storage, aliquot and store at -20°C or below. Storage in frost free freezers is not recommended. Avoid repeated freeze/thaw cycles. Suggest spin the vial prior to opening. The antibody solution should be gently mixed before use. |
| Note | For laboratory research only, not for drug, diagnostic or other use. |
Bioinformation
| Database Links | |
|---|---|
| Background | The protein encoded by this gene belongs to the aconitase/IPM isomerase family. It is an enzyme that catalyzes the interconversion of citrate to isocitrate via cis-aconitate in the second step of the TCA cycle. This protein is encoded in the nucleus and functions in the mitochondrion. It was found to be one of the mitochondrial matrix proteins that are preferentially degraded by the serine protease 15(PRSS15), also known as Lon protease, after oxidative modification. [provided by RefSeq, Jul 2008] |
| Highlight | Related products: Aconitase antibodies; Aconitase ELISA Kits; Anti-Goat IgG secondary antibodies; Related news: TCA intermediate fumarate promotes mitobiogenesis |
| Research Area | Controls and Markers antibody; Metabolism antibody; Signaling Transduction antibody |
| Calculated MW | 85 kDa |
Images (4) Click the Picture to Zoom In
-
ARG65168 anti-ACO2 / Aconitase 2 antibody WB image
Western blot: Human Heart lysate (35 µg protein in RIPA buffer) stained with ARG65168 anti-ACO2 / Aconitase 2 antibody at 0.01 µg/ml dilution.
-
ARG65168 anti-ACO2 / Aconitase 2 antibody WB image
Western blot: Human (A), Mouse (B) and Rat (C) Adipose lysates (35 µg protein in RIPA buffer) stained with ARG65168 anti-ACO2 / Aconitase 2 antibody at 0.1 µg/ml dilution.
-
ARG65168 anti-ACO2 / Aconitase 2 antibody WB image
Western blot: Mouse (A), Rat (B) and Pig (C) Skeletal Muscle lysates (35 µg protein in RIPA buffer) stained with ARG65168 anti-ACO2 / Aconitase 2 antibody at 0.01 µg/ml dilution.
-
ARG65168 anti-ACO2 / Aconitase 2 antibody IHC-P image
Immunohistochemistry: Paraffin-embedded Human breast. Antigen Retrieval: Steamed with Citrate buffer (pH 6.0). Tissue were stained with ARG65168 anti-ACO2 / Aconitase 2 antibody at 3.8 µg/ml dilution followed by AP-staining.